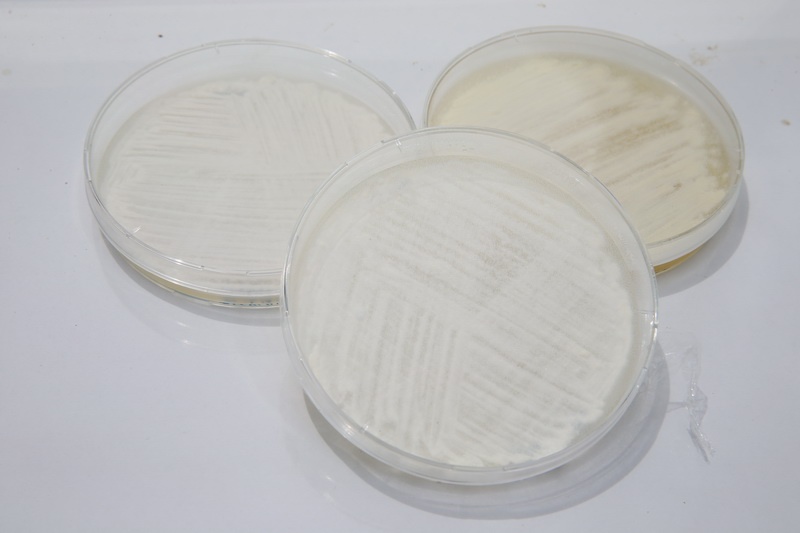
A23Y3859.JPG

กระทรวงวิทยาศาสตร์และเทคโนโลยี (วท.)
เป็นหน่วยงานของรัฐที่จัดตั้งขึ้นเพื่อการพัฒนาวิทยาศาสตร์ เทคโนโลยี และนวัตกรรม สร้างความสามารถในการแข่งขันของประเทศอย่างยั่งยืน ไม่ได้มีวัตถุประสงค์เพื่อแสวงหากำไร
หากท่านพบว่ามีข้อมูลใดๆ ที่ละเมิดทรัพย์สินทางปัญญาปรากฏอยู่ในเว็บไซต์ของกระทรวงวิทยาศาสตร์และเทคโนโลยี
โปรดแจ้งให้ทราบเพื่อดำเนินการแก้ปัญหาดังกล่าวโดยเร็วที่สุดต่อไป